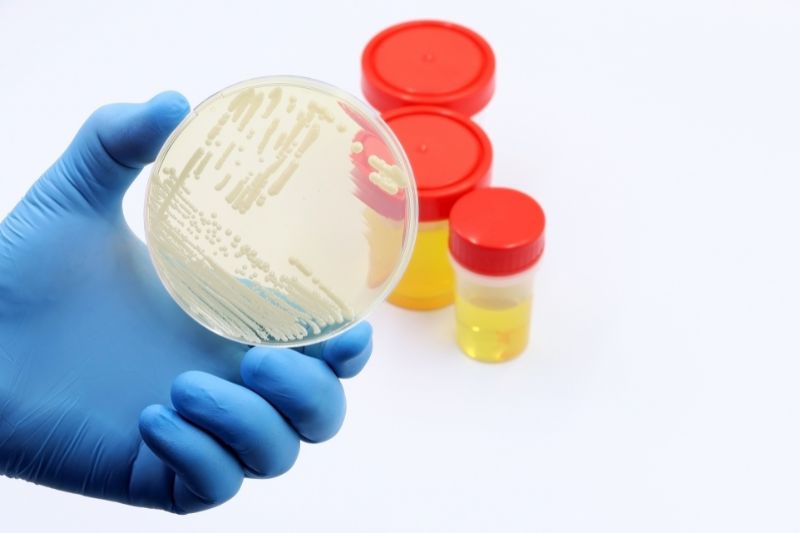
Batteriuria: cosa significa trovare batteri nelle urine e quando preoccuparsi

La batteriuria indica la presenza di batteri nelle urine. È un riscontro piuttosto frequente, soprattutto negli esami di routine, e può avere significati diversi a seconda del contesto clinico.
In alcuni casi è associata a un’infezione delle vie urinarie, in altri può essere del tutto asintomatica e priva di conseguenze cliniche rilevanti. Proprio per questo motivo, interpretare correttamente la batteriuria è fondamentale per evitare sia trattamenti inutili sia il rischio di trascurare condizioni che richiedono attenzione.
Capire quando rappresenta un problema e quando no permette di gestire la situazione in modo più consapevole e mirato.
Cosa significa avere batteri nelle urine
La presenza di batteri nelle urine indica che microrganismi sono entrati nelle vie urinarie, che comprendono uretra, vescica, ureteri e reni.
In condizioni fisiologiche, l’urina è sterile. Tuttavia, durante il percorso di eliminazione, può venire a contatto con batteri provenienti dall’esterno, soprattutto dalla regione perineale. Questo rende fondamentale distinguere tra una reale presenza di batteri nelle vie urinarie e una semplice contaminazione del campione.
Per questo motivo, nella pratica clinica si considera significativa una batteriuria quando il numero di batteri supera una certa soglia nell’urinocoltura, in particolare in presenza di campioni raccolti correttamente.
Una raccolta non adeguata, ad esempio senza scartare il primo getto o senza una corretta igiene preliminare, può portare a risultati falsati, con il rischio di interpretazioni non corrette.
Batteriuria e infezione urinaria: non sono la stessa cosa
Uno degli errori più comuni è considerare automaticamente la presenza di batteri nelle urine come un’infezione urinaria.
In realtà, la diagnosi di infezione delle vie urinarie richiede la presenza contemporanea di batteriuria e sintomi clinici. I sintomi più tipici includono bruciore durante la minzione, aumento della frequenza urinaria, urgenza minzionale e, in alcuni casi, dolore sovrapubico o lombare.
In assenza di questi segni, la semplice presenza di batteri prende il nome di batteriuria asintomatica, una condizione che nella maggior parte dei casi non comporta conseguenze e non richiede trattamento.
Questa distinzione è particolarmente importante per evitare l’uso improprio di antibiotici, che può contribuire allo sviluppo di resistenze batteriche e alterare l’equilibrio della flora microbica.
Cos’è la batteriuria asintomatica
La batteriuria asintomatica si verifica quando i batteri sono presenti nelle urine ma non provocano alcun sintomo.
È una condizione relativamente frequente e può essere osservata con maggiore incidenza in alcune categorie di pazienti. Nelle donne, ad esempio, la conformazione anatomica dell’uretra facilita la risalita dei batteri. Negli anziani, invece, fattori come ridotta mobilità, svuotamento incompleto della vescica o comorbidità possono favorire la colonizzazione batterica.
Anche l’utilizzo prolungato di cateteri urinari rappresenta una condizione in cui la presenza di batteri è molto comune e spesso inevitabile.
Nella maggior parte dei casi, la batteriuria asintomatica non evolve in infezione e non richiede trattamento. Intervenire con antibiotici in queste situazioni non porta benefici e può, al contrario, aumentare il rischio di selezione di batteri resistenti.
Quando la batteriuria va trattata
Il trattamento della batteriuria dipende dal contesto clinico e dalla presenza o meno di sintomi.
Quando la batteriuria è associata a sintomi urinari, si configura un quadro di infezione delle vie urinarie, che può interessare la vescica (cistite) o, nei casi più complessi, i reni (pielonefrite). In queste situazioni è indicata una terapia antibiotica mirata, basata possibilmente sui risultati dell’urinocoltura.
Esistono però condizioni particolari in cui la batteriuria deve essere trattata anche in assenza di sintomi. Questo avviene, ad esempio, in gravidanza, dove la presenza di batteri nelle urine può aumentare il rischio di complicanze come infezioni renali o parto pretermine.
Un’altra situazione riguarda i pazienti che devono sottoporsi a procedure urologiche invasive, in cui la presenza di batteri può aumentare il rischio di infezioni sistemiche.
Come si diagnostica la batteriuria
La diagnosi di batteriuria si basa su una combinazione di esami di laboratorio.
L’esame delle urine rappresenta il primo livello di indagine e può evidenziare segni indiretti di infezione, come la presenza di leucociti, nitriti o alterazioni del pH urinario.
L’urinocoltura, invece, è l’esame di riferimento perché consente di identificare con precisione il tipo di batterio presente e di quantificarne la concentrazione. Inoltre, permette di eseguire un antibiogramma, fondamentale per scegliere l’antibiotico più efficace.
La qualità del campione è un elemento cruciale: una raccolta non corretta può compromettere l’attendibilità del risultato e rendere necessario ripetere l’esame.
Cause più comuni della batteriuria
Nella maggior parte dei casi, i batteri responsabili della batteriuria provengono dalla flora intestinale. Il microrganismo più frequentemente coinvolto è Escherichia coli, che possiede caratteristiche che facilitano l’adesione alle pareti delle vie urinarie.
Altri batteri possono essere coinvolti, soprattutto in contesti clinici particolari, come pazienti ospedalizzati o portatori di catetere.
La comparsa di batteri nelle urine può essere favorita da diversi fattori, tra cui il ristagno urinario, che crea un ambiente favorevole alla proliferazione batterica. Anche condizioni come l’ipertrofia prostatica nell’uomo o alterazioni anatomiche delle vie urinarie possono contribuire a questo fenomeno.
Batteriuria e prevenzione
La prevenzione della batteriuria, soprattutto nei soggetti predisposti, passa attraverso una serie di accorgimenti legati allo stile di vita.
Una adeguata idratazione favorisce il flusso urinario e contribuisce a ridurre la permanenza dei batteri nelle vie urinarie. Anche lo svuotamento regolare della vescica è un elemento importante, in quanto il ristagno urinario rappresenta un fattore di rischio.
L’igiene intima deve essere corretta ma non eccessiva, per evitare alterazioni della flora batterica locale. Nelle donne, alcune semplici attenzioni quotidiane possono ridurre il rischio di contaminazione batterica.
Nei soggetti con infezioni ricorrenti, il medico può valutare strategie preventive specifiche, che possono includere interventi comportamentali o, in alcuni casi, approcci terapeutici mirati.
Quando rivolgersi allo specialista
La presenza occasionale di batteri nelle urine, soprattutto se isolata e priva di sintomi, non rappresenta necessariamente un problema.
È invece opportuno rivolgersi a uno specialista quando si verificano sintomi persistenti o ricorrenti, quando le infezioni delle vie urinarie si ripresentano con frequenza o quando gli esami mostrano alterazioni ripetute nel tempo.
Una valutazione urologica consente di individuare eventuali cause sottostanti, distinguere tra colonizzazione e infezione e impostare un percorso diagnostico e terapeutico adeguato.
La batteriuria è un riscontro comune, ma il suo significato varia in base al contesto. Una corretta interpretazione consente di evitare interventi non necessari e di intervenire in modo mirato quando serve, migliorando la gestione della salute urinaria nel lungo periodo.
Visita Urologica in Provincia di Lecce
Se hai bisogno di una Visita Urologica in Provincia di Lecce, puoi fissare un appuntamento con il dottor Alessandro Distante, urologo di SB Medical a Corsano.
Ecco come raggiungerci.